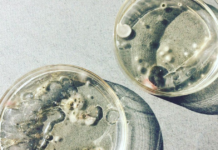
Стоит ли беспокоиться о формальдегиде в косметических продуктах?

Как выбрать косметику через интернет магазин?
Прежде чем покупать косметику в интернет магазине, нужно узнать информацию о продавце. Эта информация важна для того, чтобы не нарваться на мошенников. Чем удобны...
Стоит ли беспокоиться о формальдегиде в косметических продуктах?
Стоит ли беспокоиться о формальдегиде
в косметических продуктах?
Нет никаких сомнений в том, что осведомленность и дискуссии об ингредиентах, используемых в косметических продуктах, о потенциально сомнительных...
Печать на худи: несколько технологий
Если вы хотите выглядеть стильно и оригинально, тогда лучше сделать печать на худи. Такая оригинальная толстовка с капюшоном украсит ваш образ и удивит окружающих....
Где найти хорошего парикмахера?
В настоящее время каждая девушка и женщина регулярно посещают различные салоны красоты, где есть возможность максимально преобразить себя, создать определенный образ, подкорректировать какие-то имеющиеся...
Все об автозагаре JAMES READ TAN
Брэнд James Read изобретен главным специалистом по загару. Из-за собственного необычного мнения об автозагаре, Джеймс первый заинтересовался уходом за кожей и загаром. Любая продукция...
Чем занимается врач-косметолог?
Как только у нас появляются проблемы с кожей, начинают высыпать на лице прыщи, слишком сильно открытые поры, мы сразу обращаемся к косметологу.Врачом косметологом называют...
Как выбрать серебряное кольцо с камнем?
Буквально каждая девушка и женщина любят украшать себя и свое тело, именно поэтому их так привлекают различные ювелирные украшения, которые делают их невероятно привлекательными....
Масло для волос Moroccanoil: разновидности
Регулярное окрашивание и ежедневная укладка с использованием плойки, утюжка или фена, существенно портит структуру волос, делая их тусклыми и ломкими. Вернуть утраченный блеск, сделать...
Советы по выбору женской одежды
Выглядеть красиво хотят все женщины. Но как подобрать одежду, чтобы она отлично сидела и смотрелась. При выборе гардероба нужно следовать нескольким простым правилам и...
Основные тренды 2020: что будем носить весной и летом
Мода не настолько быстротечна, как это принято считать. Многие модные тенденции уже были в моде и в прошлые сезоны. Мода, например, на перья, неоновые...